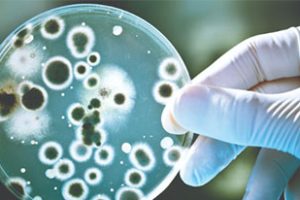

《 时间的真相 Do You Know What Time It Is? 2008 》英语中字 720P高清 – BBC纪录片下载
如果你被问到“你知道现在的时间吗”,是否会觉得这是一个太过简单的问题?
《 抗击超级细菌/战胜超级病菌 Defeating the Superbugs 2012 》英语外挂中字 720P高清 – BBC纪录片下载
抗生素是人类医学史上的一大奇迹,自诞生以来拯救了无数生命。但如今由…

《 吃得少活得久/节食与长寿 Eat, Fast and Live Longer 2012 》英语中字 720P高清 – BBC纪录片下载
肥胖是现代人类最大的敌人。那么节食是否会带来健康与长寿,这一直是人们…

《 不列颠的微型世界/英国的微小生命 Miniature Britain 2012 》英语外挂中英字幕 1080i高清 – BBC纪录片下载
纪录片中生物学家George McGavin继续环游不列颠群岛,讲述英国本土不为人…

《 恒星七纪/星光的七个时期 Seven Ages of Starlight 2012 》全2集 英语中字 标清/1080P高清 -BBC纪录片下载
每当太阳落山,夜幕降临,坐在大地,仰望星空,就能看到一部史诗巨作在眼…

《 自然的力量 Forces of Nature with Brian Cox 2016 》第1季全4集 英语中字 720P/1080i高清 – BBC纪录片下载
收藏 继《太阳系的奇迹》、《宇宙的奇迹》、《生命的奇迹》(和《人类宇宙》之后,物理学家布莱恩·考克斯(Bria…